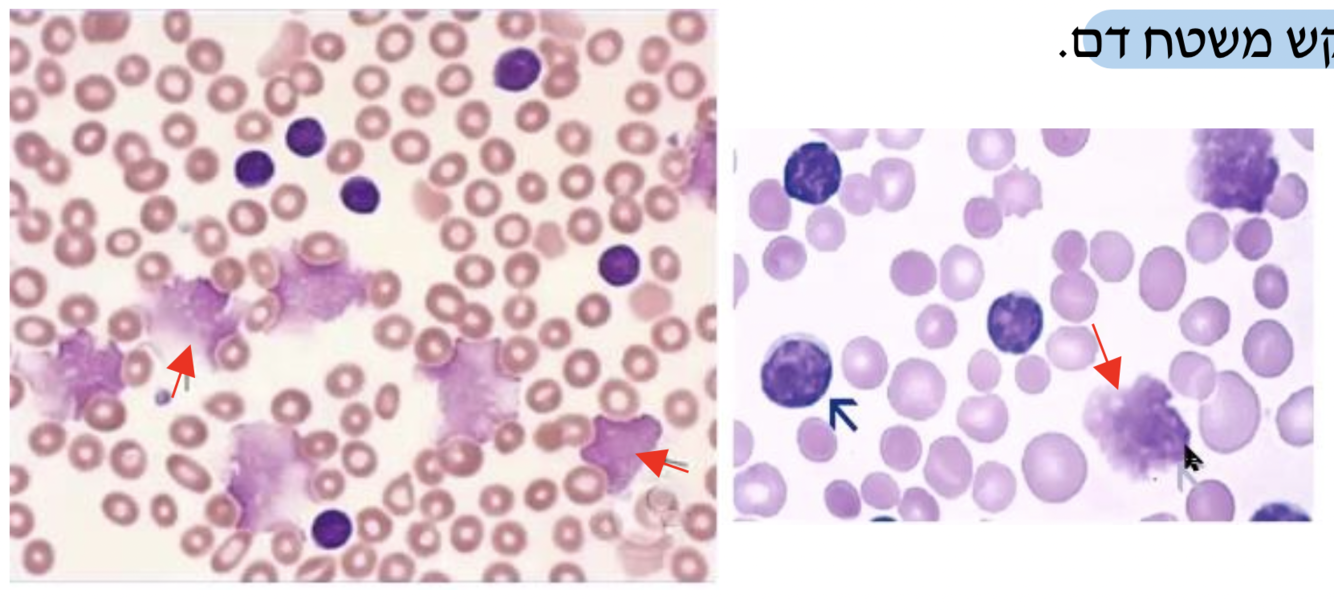

מהו לויקוציטוזיס? מה הגורם השכיח ללויקוציטוזיס? ומתי זה מחשיד לבעיה במח העצם?
הרבה לויקוציטים,
הסיבה הכי שכיחה היא זיהום, ובו הספירה תעלה ל16-20 אלף
כאשר זה מעבר למספרים האלו זה מייצג זיהום קשה בטיפול נמרץ/ אדם במצב כללי טוב עם בעיה במח העצם.
אם יש בעיה במח העצם נראה גם אנמיה קלה וירידה בטסיות.
CLL מה נראה הסטולוגית ב?
תאי סל!!! לימפוציטים שנשברים בגלל מבנה ממברנה לא תקין.
נראה בדיפרנציאל בדם משמעותית יותר לימפוציטים מנויטרופילים.
מהי הלוקמיה הכי שכיחה?
CLL
גיל חציוני הוא 72- מחלה של מבוגרים
בעיקר גברים יהודים אשכנזים
נראה בספירה רק תאים בשלים, תאי סל.
ההגדרה היא מכל 5000 תאי לימפוציטים מסוג בי מונוקלונליים.

CLL מה המרקרים שמאפיינים לימפוציטים ב?
CD5 יש T באופן רגיל לתאי
CD19 יש B ולתאי
CD19,CD5 התאים הם CLL ב
בנוסף התאים יפרישו שרשראות קלות (קאפא או למדא) ביתר מה שמעיד על הפרשה מונוקלונלית
Flow cytometry לאבחנה אנחנו מסתפקים בספירת דם+ משטח דם+

MBL
monoclonal B cell lymphocytosis
CLL מצב שקודם ל
ספירת דם תקינה עם דיפרנציאל לא תקין

CLL מה ההתייצגות הקלינית של?
לימפה, טחול, אנמיה, טרומסוציטופניה, אוטואימוניות המטולוגית, בי סימפטומס.

CLL מה הפרוגנוזה הכללית ל?
ומה נחשב לגורם פרוגנוסטי גרוע?
תוחלת חיים של כ10 שנים
17p deletion- גורם פרוגנוסטי גרוע של מחלה עמידה לכימו.
P53 באיזור הזה יושב הגן
בנוסף התאים מחולקים לכאלו עם מוטציה וכאלו בלי, המוטציה עדיפה פרוגנוסטית כי זה אומר שהתא יותר בשל. תא יותר בשל הוא תא פחות אגרסיבי.

CLL מתי צריך לתת טיפול ל?
אנמיה או טרומבוציטופניה
טחול מוגדל
הגדלת בלוטות לימפה
לימפוציטוזיס מהיר
חולים עם תופעות אוטואימוניות
B symptoms
CLL טיפולים ל

